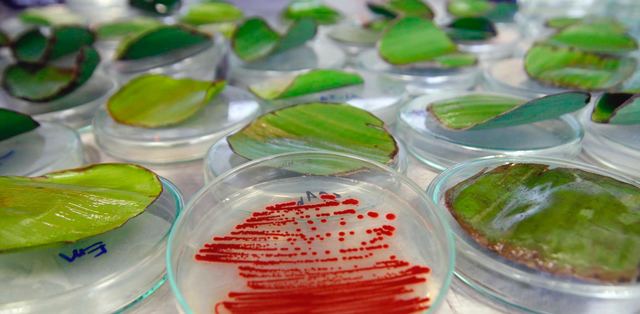
Aparicion de la Biotecnologia

-
Robet Hooke, en su famoso libro Micrographia, fue el primero a dedicarse a observaciones microscópicas,describió los cuerpos fructificantes de los mohos,la cual representa la primera descripción de microorganismos.
-
Su trabajo más famoso fue un trabajo titulado "Experimentos en la Generación de los Insectos" que publicó en 1668. Este trabajo proporcionó pruebas contra la teoría de la generación espontánea.Ademas de proporcionar experimentos controlados,también realizo estudios sobre el veneno de las viboras y escribió "Observaciones en torno a las víboras".
-
Antoni van leeuwenhoek,empleo con un microscopio simple de construcción propia para examinar el contenido microbiano de varias sustancias naturales,con ello en 1676,describio sus observaciones en una serie de cartas dirigidas al Royal Society de Londres.
-
Fue uno de los primeros cientificos que reconocio la importancia de los isomeros opticos,tienes muchas aportaciones como el descubrimiento del hongo "Aspergillus".
Sus trabajos de asimetria lo llevaron a el analisis de las fermentaciones entre ella la alcoholica, que se demostraron estaba catalizada por las levaduras y desmentir la generación espontanea,eliminando por medio de calor.
Entre otros exitos destaca el desarrollo de vacunas contra enfermedades como el carbunco,colera aviar y la rabia -
Ferdinand Cohn,pensaba que todas bacterias,incluso las que carecen de pigmentos fotosíntesis,eren miembros del reino vegetal,y sus estudios de microscopia sobre plantas y algas le condujeron gradualmente al estudio de diversas bacterias.Ademas lo llevo a descubrir bacterias que forman endoesporas,bacteria que tiene resistencia al calor. Contribuyendo de muchas maneras al desarrollo de la bacteriologia.
-
Entre sus descubrimientos podemos destacar: los métodos de estudio de bacterias de cultivo axenico,es decir poder cultivar la bacteria en caldos nutritivos.
La etiologia de la tuberculosis y la etiologia del colera
Y los postulados de Koch para demostrar que un tipo concreto de microorganismos es el agente etiologico de una enfermedad. -
Demostró que existían determinadas bacterias relacionadas con transformaciones biogeoquimicas especificas.
Propuso el concepto de "quimiolitotrofia",es decir,la oxidación de compuestos inorgánico acoplada a la obtención de energía utilizable. También aisló la primera bacteria fijadora de nitrógeno,la bacteria anaerobia "Clostridium pasteurianum" y desarrollo la noción de fijación de nitrógeno
Hizo descubrimiento para lograr el aislamiento de bacterias fijadoras de nitrógeno pero aerobias. -
El muestreo de los genes del RNA ribosomal revela la enorme diversidad bacteriana en la naturaleza
-
Las aportaciones mas importantes al campo de la microbiologia fue la formulación de la técnica del cultivo de enriquecimiento(los microorganismos se aíslan de muestras naturales de un modo muy selectivo mediante la manipulación de las condiciones nutricionales y de incubación).Describio el primer virus ,el del tabaco,estableciendo los principios básicos de la virologia.
-
Con el avance en la microbiologia se diron lugar a areas para clasificar a los microorganismos.
Debido a que se han cultivado microorganismos nuevos se origino la sistemática microbiana,la ciencia que agrupa y clasifica los microorganismos.
El estudio de los nutrientes que requieren los microorganismos y los productos dieron origen a la Fisiología Microbiana.
La fisiología microbiana el estudio de los nutrientes que requieren los microorganismos y los productos que requieren. -
Estructura del DNA
-
El avance de los conocimientos sobre la fisiologia,bioquimica y la genetica molecular hizo posible la manipulacion experimental del material genetico.Se desarrollaron tecnicas de secuenciacion de acidos nucleicos,y los efectos de la aplicacion de esta nueva tecnologia se notaron en todas las areas de la biologia.
-
La gran cantidad de información disponible en la actualidad sobre genes y genomas ha impulsado importantes avances en muchas áreas.
El dinámico campo ha dado origen,a su vez,a otras disciplinas como la proteomica y la metabolomica,estudian los modelos de expresion proteica y metabólica de las células.
A list shows items. A timeline shows sequence.
Use Timetoast to make dates, milestones, and turning points easier to understand in a clear visual format. Timetoast is a timeline maker for work, school, research, and stories.